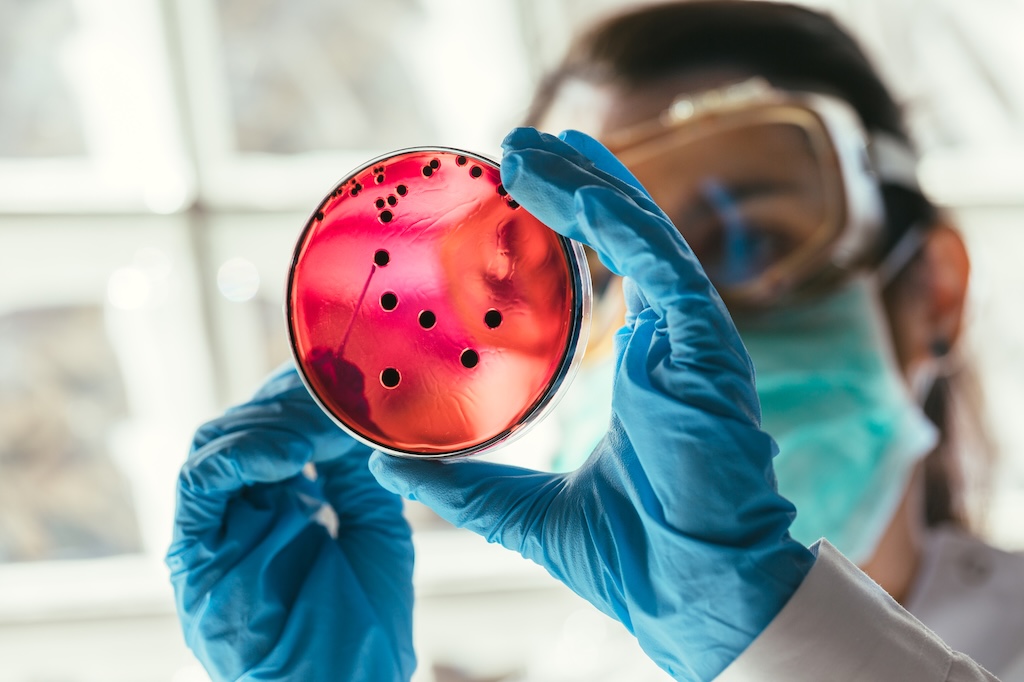

OUR IMPACT
Where Bold Ideas Become Breakthroughs
Since 2007, CBCF has driven groundbreaking discoveries that are transforming how the world understands and fights breast cancer. Unlike most funders, CBCF supports bold, paradigm-shifting research, giving scientists the freedom to pursue big ideas that others often overlook.

A new way of understanding cancer.
For decades, cancer was viewed primarily as a disease of uncontrolled cell division. CBCF supported scientists and doctors revealed something fundamental: cancer is also a disease of cell mobility. Cancer cells do not stay put. They move, spread, and even return to their original tumor in a process called self-seeding. This insight has reshaped the entire field of cancer research.
Breakthroughs We've Helped Make Possible
Established and advanced the self-seeding model of breast cancer
Demonstrating how circulating cancer cells can return to the original tumor site, making them more aggressive and fueling metastasis, the cause of most cancer deaths.
Explored the dual role of immune cells within tumors
Showing that some immune cells, mutant white blood cells, help cancer grow and resist treatment, while others can be harnessed to attack it. These insights are paving the way for new approaches in diagnostics and immunotherapy.
Advanced anti-metastasis therapies
From early studies turning tumors into “poisoned sponges” designed to attract and kill cancer cells, to today’s work on targeted drugs and CAR T cell therapies, CBCF research has pushed the frontier of how to stop cancer from spreading.
Developed predictive models of cancer spread
Using mathematical oncology and AI, CBCF scientists are creating tools to forecast how cancer will grow and where it will spread, helping doctors tailor treatments more precisely.
Linked bone health and breast cancer
Revealing how breast cancer cells can hide in bone for decades, and how bone biology may influence cancer’s return. This research is informing prevention and treatment strategies worldwide.
Pioneered clinical progress
Discoveries supported by CBCF underlie advances in dose-dense chemotherapy, new immunotherapy approaches, and novel drugs that block cancer cell movement, innovations with the potential to transform care for breast cancer patients.

Why it matters.
Every leap forward in understanding cancer biology creates ripple effects across treatment, prevention, and survivorship. Thanks to CBCF supporters, scientists now know that defeating breast cancer requires targeting both how cancer cells divide and how they move. This knowledge is already shaping new therapies and giving hope for strategies that prevent cancer before it takes hold.
Looking ahead.
CBCF research is not about incremental steps, it is about bold leaps toward a cure. By funding fundamental science into cell mobility, metastasis, and the tumor microenvironment, CBCF is accelerating discoveries that can eliminate breast cancer at its roots. Together, we are not just treating cancer, we are working to end it.
Join Our Mailing List.
Sign up and stay informed about our events, news and research initiatives.
